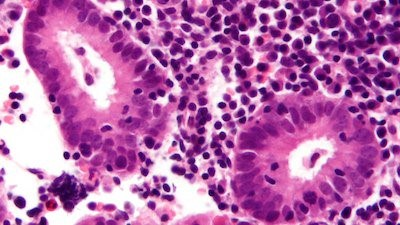

Có một thời điểm Thu nhận ra làn da không còn phản ứng nhanh như trước một số chị em sau tuổi 35 cũng gặp phải tình trạng này. Một vết mụn mất lâu hơn để lành. Da không còn căng tự nhiên dù vẫn dùng những sản phẩm quen thuộc. Cảm giác cơ thể cũng không còn dẻo dai như trước, đặc biệt là sau những ngày làm việc căng thẳng.
Những thay đổi đó không đến đột ngột, nhưng đủ để khiến Thu bắt đầu tìm hiểu sâu hơn về một thứ mà trước đây chỉ nghe qua rất nhiều lần, đó là collagen. Khi hiểu rõ bản chất, Thu nhận ra việc BỔ SUNG COLLAGEN ĐÚNG CÁCH không phải là chạy theo xu hướng, mà là hiểu cơ thể mình đang thiếu gì theo thời gian.

Collagen là gì và vì sao lại quan trọng với phụ nữ sau 35?
Collagen có nguồn gốc từ tiếng Hy Lạp “kólla”, nghĩa là keo dán. Nghe đơn giản nhưng lại rất đúng. Collagen giống như một lớp keo giúp giữ các mô tế bào trong cơ thể liên kết chặt chẽ với nhau.
Đây là loại protein dồi dào nhất trong cơ thể, chiếm khoảng 25 đến 35 phần trăm tổng lượng protein. Nó có mặt ở da, xương, gân, sụn và cả mạch máu. Khi collagen đủ, da có độ đàn hồi, khớp vận động trơn tru và cơ thể giữ được sự săn chắc tự nhiên.
Điều đặc biệt là cấu trúc collagen không giống những protein thông thường. Nó được tạo thành từ chuỗi xoắn ba, gồm ba axit amin chính là glycine, proline và hydroxyproline. Chính cấu trúc này tạo nên độ bền và sự linh hoạt cho mô liên kết.
Khi hiểu rõ điều này, Thu nhận ra việc BỔ SUNG COLLAGEN ĐÚNG CÁCH không chỉ là để đẹp da, mà là để duy trì sự vững chắc của toàn bộ cơ thể.

Các loại collagen phổ biến trong cơ thể
Cơ thể con người có ít nhất từ 16 đến 28 loại collagen khác nhau. Tuy nhiên, phần lớn chúng ta thường nghe đến một vài loại chính vì chúng chiếm hơn 90 phần trăm tổng lượng collagen.
Collagen loại I là loại phổ biến nhất, có nhiều ở da, xương và gân. Đây là loại quyết định độ săn chắc và đàn hồi của làn da. Khi loại này suy giảm, da bắt đầu chảy xệ và xuất hiện nếp nhăn.
Collagen loại II chủ yếu có trong sụn, đóng vai trò quan trọng với khớp. Khi thiếu hụt, cơ thể dễ cảm thấy cứng khớp hoặc kém linh hoạt.
Collagen loại III hỗ trợ cấu trúc của cơ bắp và mạch máu. Loại này thường đi cùng collagen loại I và góp phần duy trì độ mềm mại của mô.
Collagen loại IV có mặt ở màng đáy của da, liên quan đến quá trình lọc và tái tạo tế bào.
Hiểu được các loại collagen giúp Thu không còn nhìn nhận việc BỔ SUNG COLLAGEN ĐÚNG CÁCH theo một hướng đơn giản, mà hiểu rằng mỗi loại collagen đều có vai trò riêng trong cơ thể.

Vì sao collagen suy giảm nhanh sau tuổi 25?
Sau 25 tuổi, cơ thể bắt đầu giảm dần khả năng tự tổng hợp collagen. Quá trình này diễn ra chậm nhưng liên tục. Đến 35 tuổi, nhiều phụ nữ bắt đầu thấy rõ sự thay đổi.
Da không còn căng mịn. Nếp nhăn xuất hiện rõ hơn. Tóc và móng cũng yếu hơn. Không chỉ là vấn đề thẩm mỹ, mà còn liên quan đến sức khỏe tổng thể.
Ngoài tuổi tác, có những yếu tố khiến collagen suy giảm nhanh hơn. Ánh nắng mặt trời là một trong những nguyên nhân lớn nhất. Tia cực tím phá vỡ cấu trúc collagen dưới da, khiến da nhanh lão hóa.
Thói quen hút thuốc cũng làm giảm khả năng sản xuất collagen và khiến da xỉn màu. Bên cạnh đó, việc tiêu thụ nhiều đường tinh luyện dẫn đến quá trình glycation, làm sợi collagen trở nên giòn và dễ gãy.
Khi hiểu những nguyên nhân này, Thu nhận ra việc BỔ SUNG COLLAGEN ĐÚNG CÁCH không chỉ là thêm vào, mà còn là giảm bớt những thói quen làm mất đi collagen mỗi ngày.

Collagen không chỉ là câu chuyện của làn da
Nhiều người nghĩ collagen chỉ liên quan đến da. Nhưng thực tế, collagen có mặt ở hầu hết các mô trong cơ thể.
Khi collagen giảm, không chỉ da bị ảnh hưởng mà khớp cũng kém linh hoạt hơn. Cơ thể dễ mỏi hơn. Quá trình phục hồi sau vận động cũng chậm lại.
Thu nhận ra rằng cảm giác “cơ thể không còn như trước” không chỉ do tuổi tác, mà còn do sự suy giảm của collagen. Điều này khiến Thu thay đổi cách nhìn về việc chăm sóc cơ thể.
Việc BỔ SUNG COLLAGEN ĐÚNG CÁCH vì thế không phải để quay lại tuổi 20, mà để giữ cơ thể khỏe mạnh và linh hoạt theo đúng độ tuổi.
Hiểu đúng để không chạy theo xu hướng
Có một thời gian collagen trở thành xu hướng. Ai cũng nói về collagen. Nhưng không phải ai cũng hiểu rõ mình đang bổ sung cái gì và vì sao cần bổ sung.
Thu từng nghĩ chỉ cần uống collagen là đủ. Nhưng sau khi tìm hiểu, Thu nhận ra cơ thể cần nhiều yếu tố để sử dụng được collagen hiệu quả. Dinh dưỡng, giấc ngủ và lối sống đều đóng vai trò quan trọng.
Nếu cơ thể thiếu nền tảng, việc bổ sung cũng không mang lại hiệu quả như mong đợi. Vì vậy, BỔ SUNG COLLAGEN ĐÚNG CÁCH là hiểu cơ thể mình trước, sau đó mới lựa chọn cách phù hợp.
Lối sống ảnh hưởng trực tiếp đến collagen mỗi ngày
Mỗi thói quen nhỏ đều tác động đến collagen. Ngủ không đủ khiến cơ thể không có thời gian phục hồi. Căng thẳng kéo dài làm hormone mất cân bằng và ảnh hưởng đến quá trình tái tạo mô.
Chế độ ăn thiếu dinh dưỡng khiến cơ thể không có nguyên liệu để sản xuất collagen. Trong khi đó, ánh nắng và ô nhiễm môi trường lại liên tục phá vỡ những gì cơ thể đã tạo ra.
Khi nhìn lại lối sống của mình, Thu hiểu rằng việc BỔ SUNG COLLAGEN ĐÚNG CÁCH không thể tách rời khỏi cách mình sống mỗi ngày.
Chăm sóc collagen là một hành trình lâu dài
Không có giải pháp nào giúp collagen tăng lên chỉ sau vài ngày. Đây là quá trình cần thời gian và sự kiên trì.
Thu không còn tìm kiếm kết quả nhanh. Thay vào đó, Thu tập trung vào việc duy trì những thói quen tốt. Ăn uống cân bằng hơn. Ngủ đủ hơn. Giảm căng thẳng.
Khi cơ thể được chăm sóc đúng cách, collagen sẽ được bảo vệ tốt hơn và suy giảm chậm lại.
Ở tuổi 35 trở đi, cơ thể không cần những thay đổi cực đoan. Điều cần là sự ổn định và bền vững. Khi hiểu rõ và BỔ SUNG COLLAGEN ĐÚNG CÁCH, chúng ta không chỉ giữ được làn da tươi tắn mà còn giữ được sự dẻo dai và năng lượng từ bên trong.
Thu tin rằng, thanh xuân không nằm ở việc níu giữ thời gian, mà nằm ở cách chúng ta chăm sóc cơ thể mình mỗi ngày.